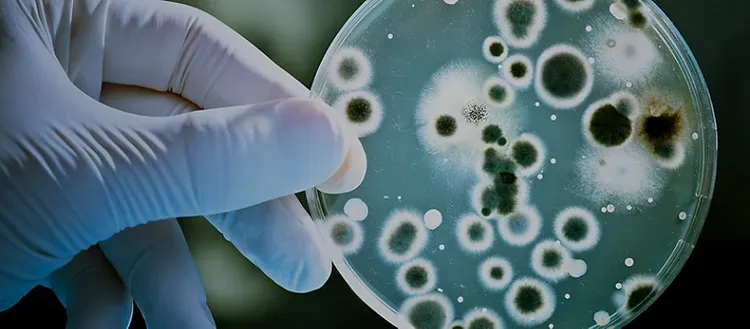
A microscopic view of some organism on a slide

<h3>Different industries. Similar digital goals.</h3> <p>All industries are different and face diverse business requirements.</p> <p>Still, most enterprises have at least two things in common: the need to evolve business models and generate new growth, as well as a mandate to deliver quality products along with a superior customer experience.</p> <p>Cognizant combines the power of digital thinking with our unique consultative approach to help clients across industries envision, build and run more innovative enterprises.</p>
<h3>Industries we serve</h3>
Take the first step
Serving customers by looking forward as well as back is a big promise, but the power of today’s new digital capabilities is vast and growing.
Let’s talk about how digital can work for your business.